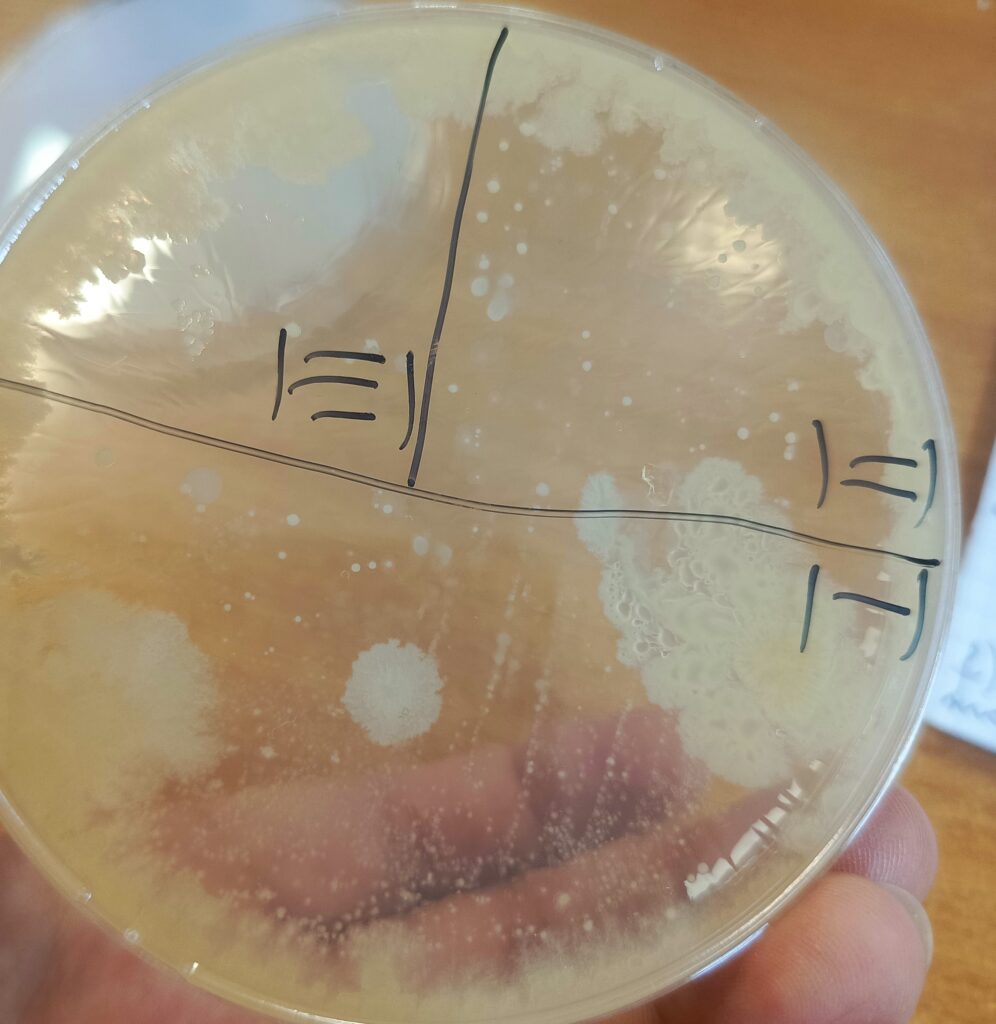
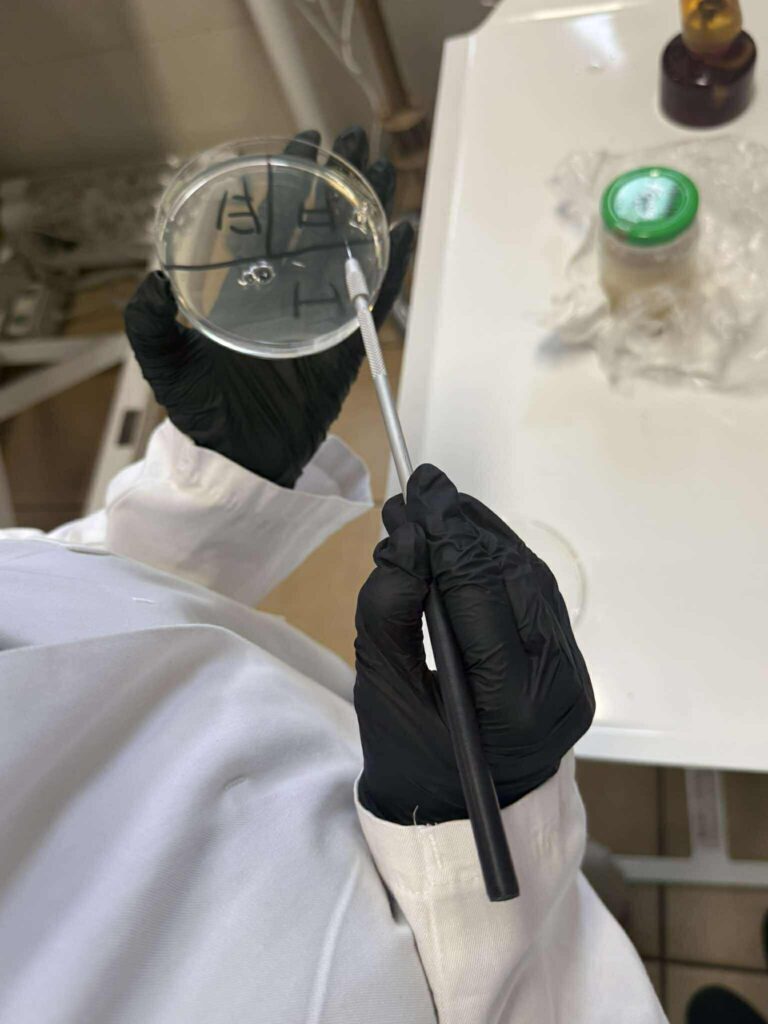

Klasy weterynaryjne ruszają do pracy już od samego początku. Tym razem uczniowie klas 4TW oraz 5TW wykonywali posiewy z próbek mleka, od krowy z zapaleniem wymienia. Jako podłoże zostało użyte PCA- podłoże do oznaczania ogólnej liczby drobnoustrojów w produktach żywnościowych. Po inkubacji i uzyskaniu pojedynczych kolonii bakteryjnych, uczniowie wykonali rozmazy, a następnie zabarwili je metodą Grama. Własnoręcznie wykonane preparaty oglądali pod mikroskopem.
Magda Kozik